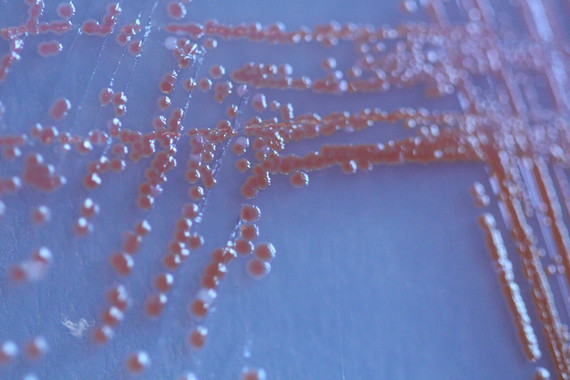
Una mutación genética en una sola especie altera ecosistemas enteros

Últimas Noticias
Lo que está pasando con los embalses en España no es casualidad pero en Países Bajos no dan crédito: «Excepcionalmente altas»
Publicado el: 22 de marzo de 2026 a las 20:42
Lucha de los científicos en el Amazonas: parece una simple planta pero lleva en la Tierra desde los dinosaurios y está a punto de desaparecer
Publicado el: 22 de marzo de 2026 a las 18:54
Científicos australianos celebran una victoria: cámaras de seguimiento captan imágenes muy extrañas de marsupiales en peligro de extinción
Publicado el: 22 de marzo de 2026 a las 15:53
Día Mundial del Agua 2026 y Global Omnium impulsan el liderazgo femenino en el ciclo integral del agua
Publicado el: 22 de marzo de 2026 a las 14:10
Tu gato no solo te lame porque te quiere mucho: el motivo real por el que lo hace, según los expertos
Publicado el: 22 de marzo de 2026 a las 12:48
Comunitat Valenciana activa alerta por especies invasoras peligrosas en ríos y humedales
Publicado el: 22 de marzo de 2026 a las 10:48
Las paredes ya pueden limpiar el aire y capturar CO₂ gracias a una pintura revolucionaria
Publicado el: 22 de marzo de 2026 a las 10:30
España celebra el Día de las Vías Pecuarias con 125.000 km clave para la biodiversidad
Publicado el: 22 de marzo de 2026 a las 09:57